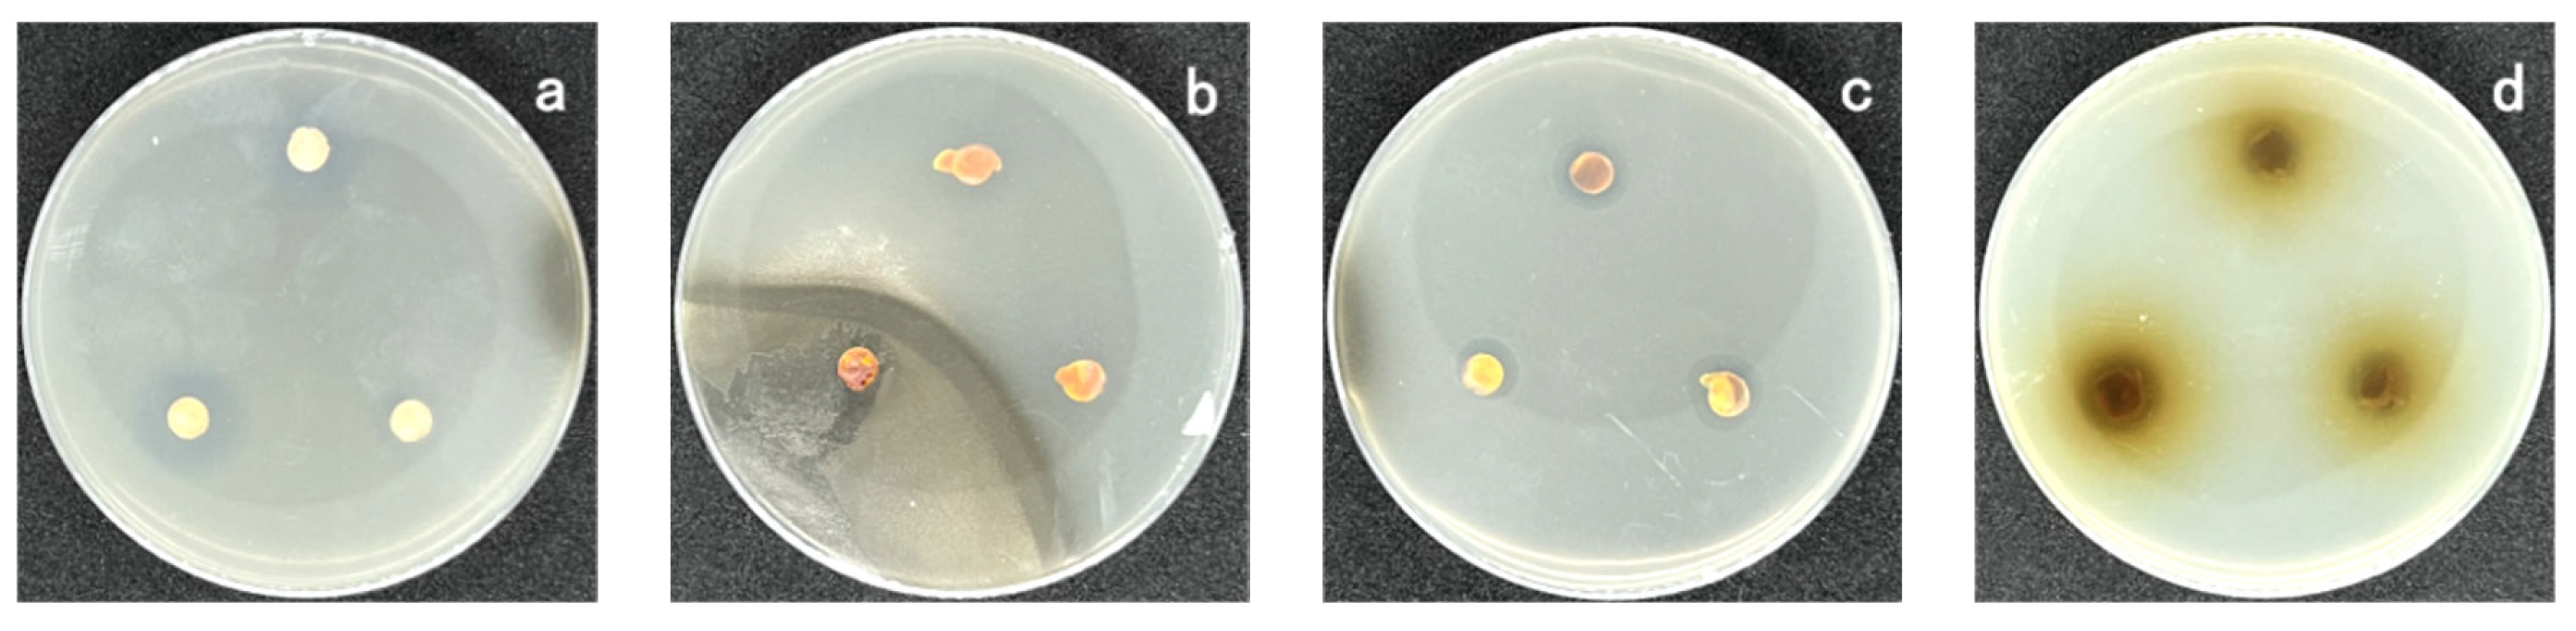
Coatings 13 00714 g002
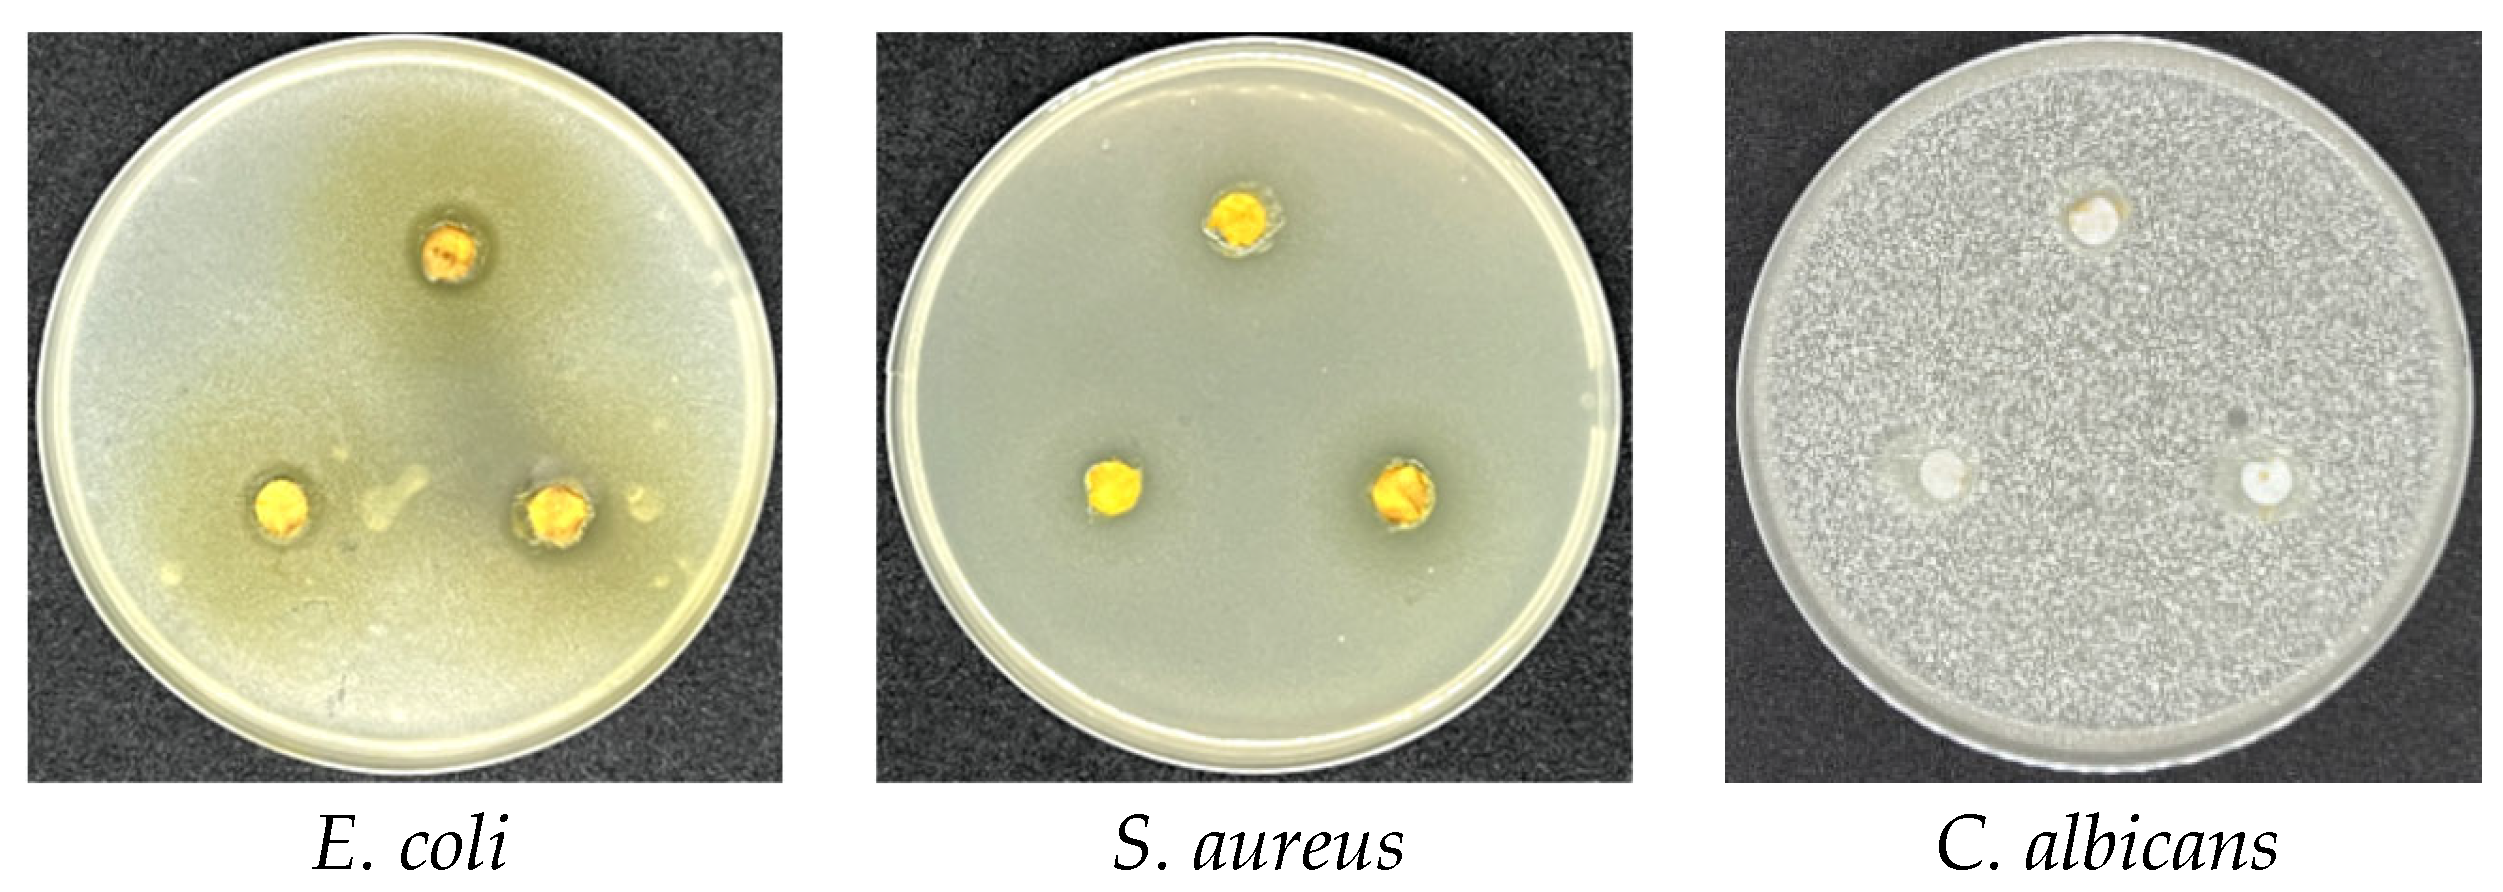
Coatings 13 00714 g010
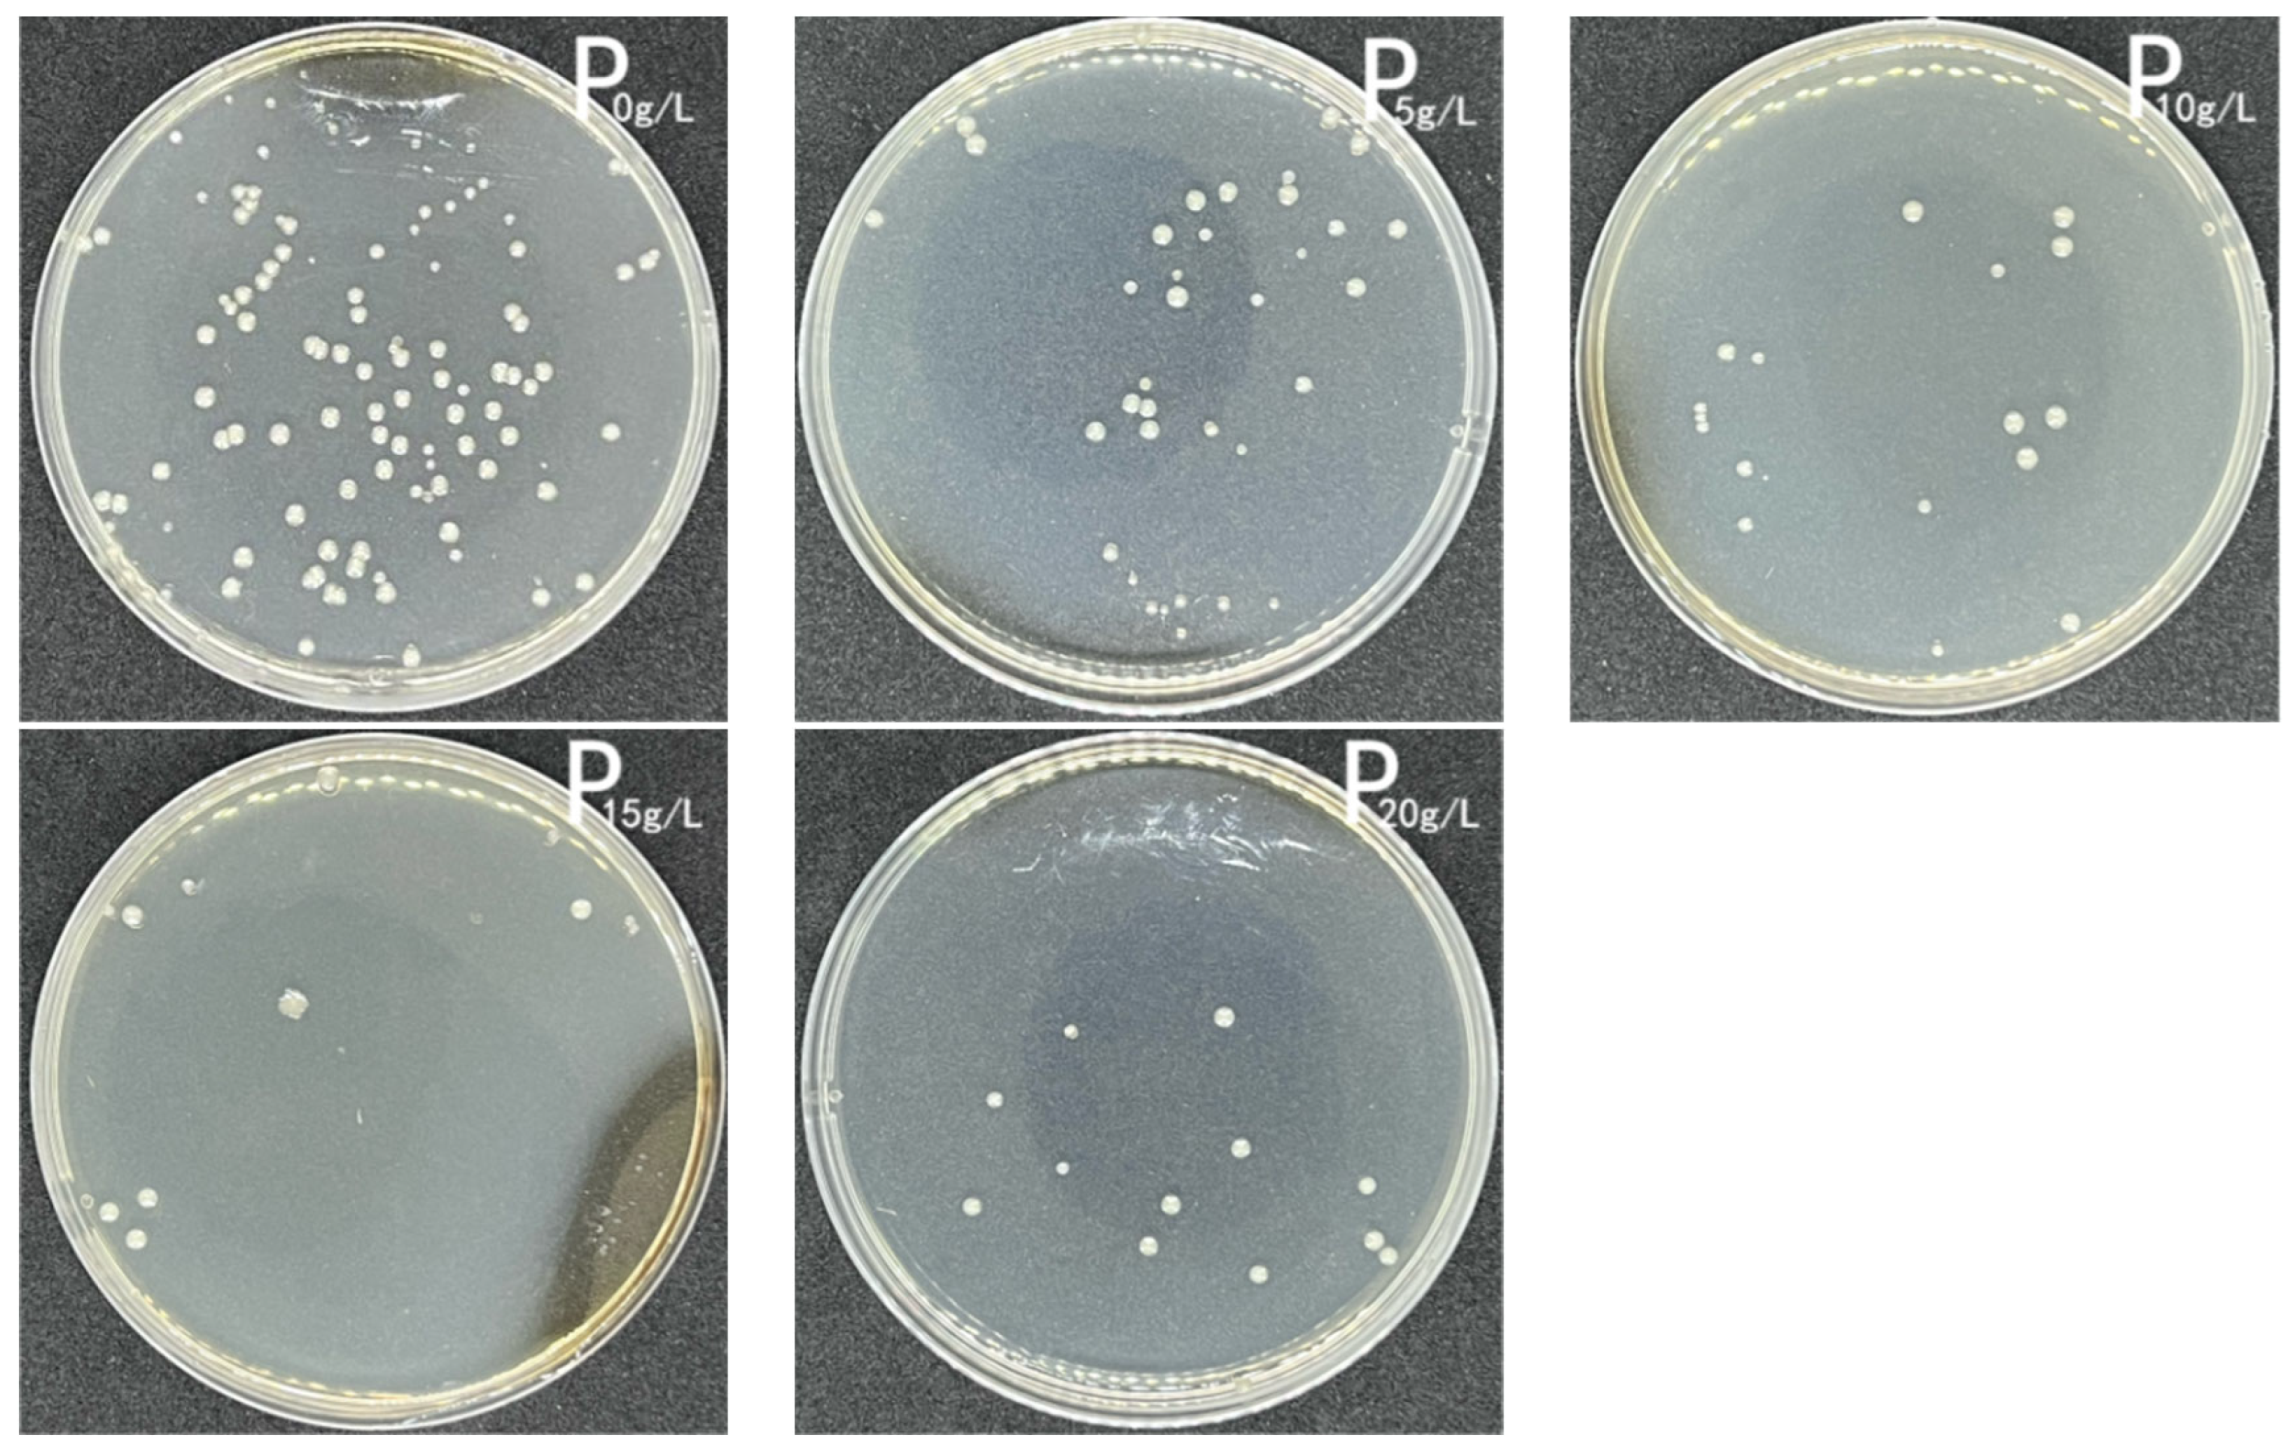
Coatings 13 00714 g012
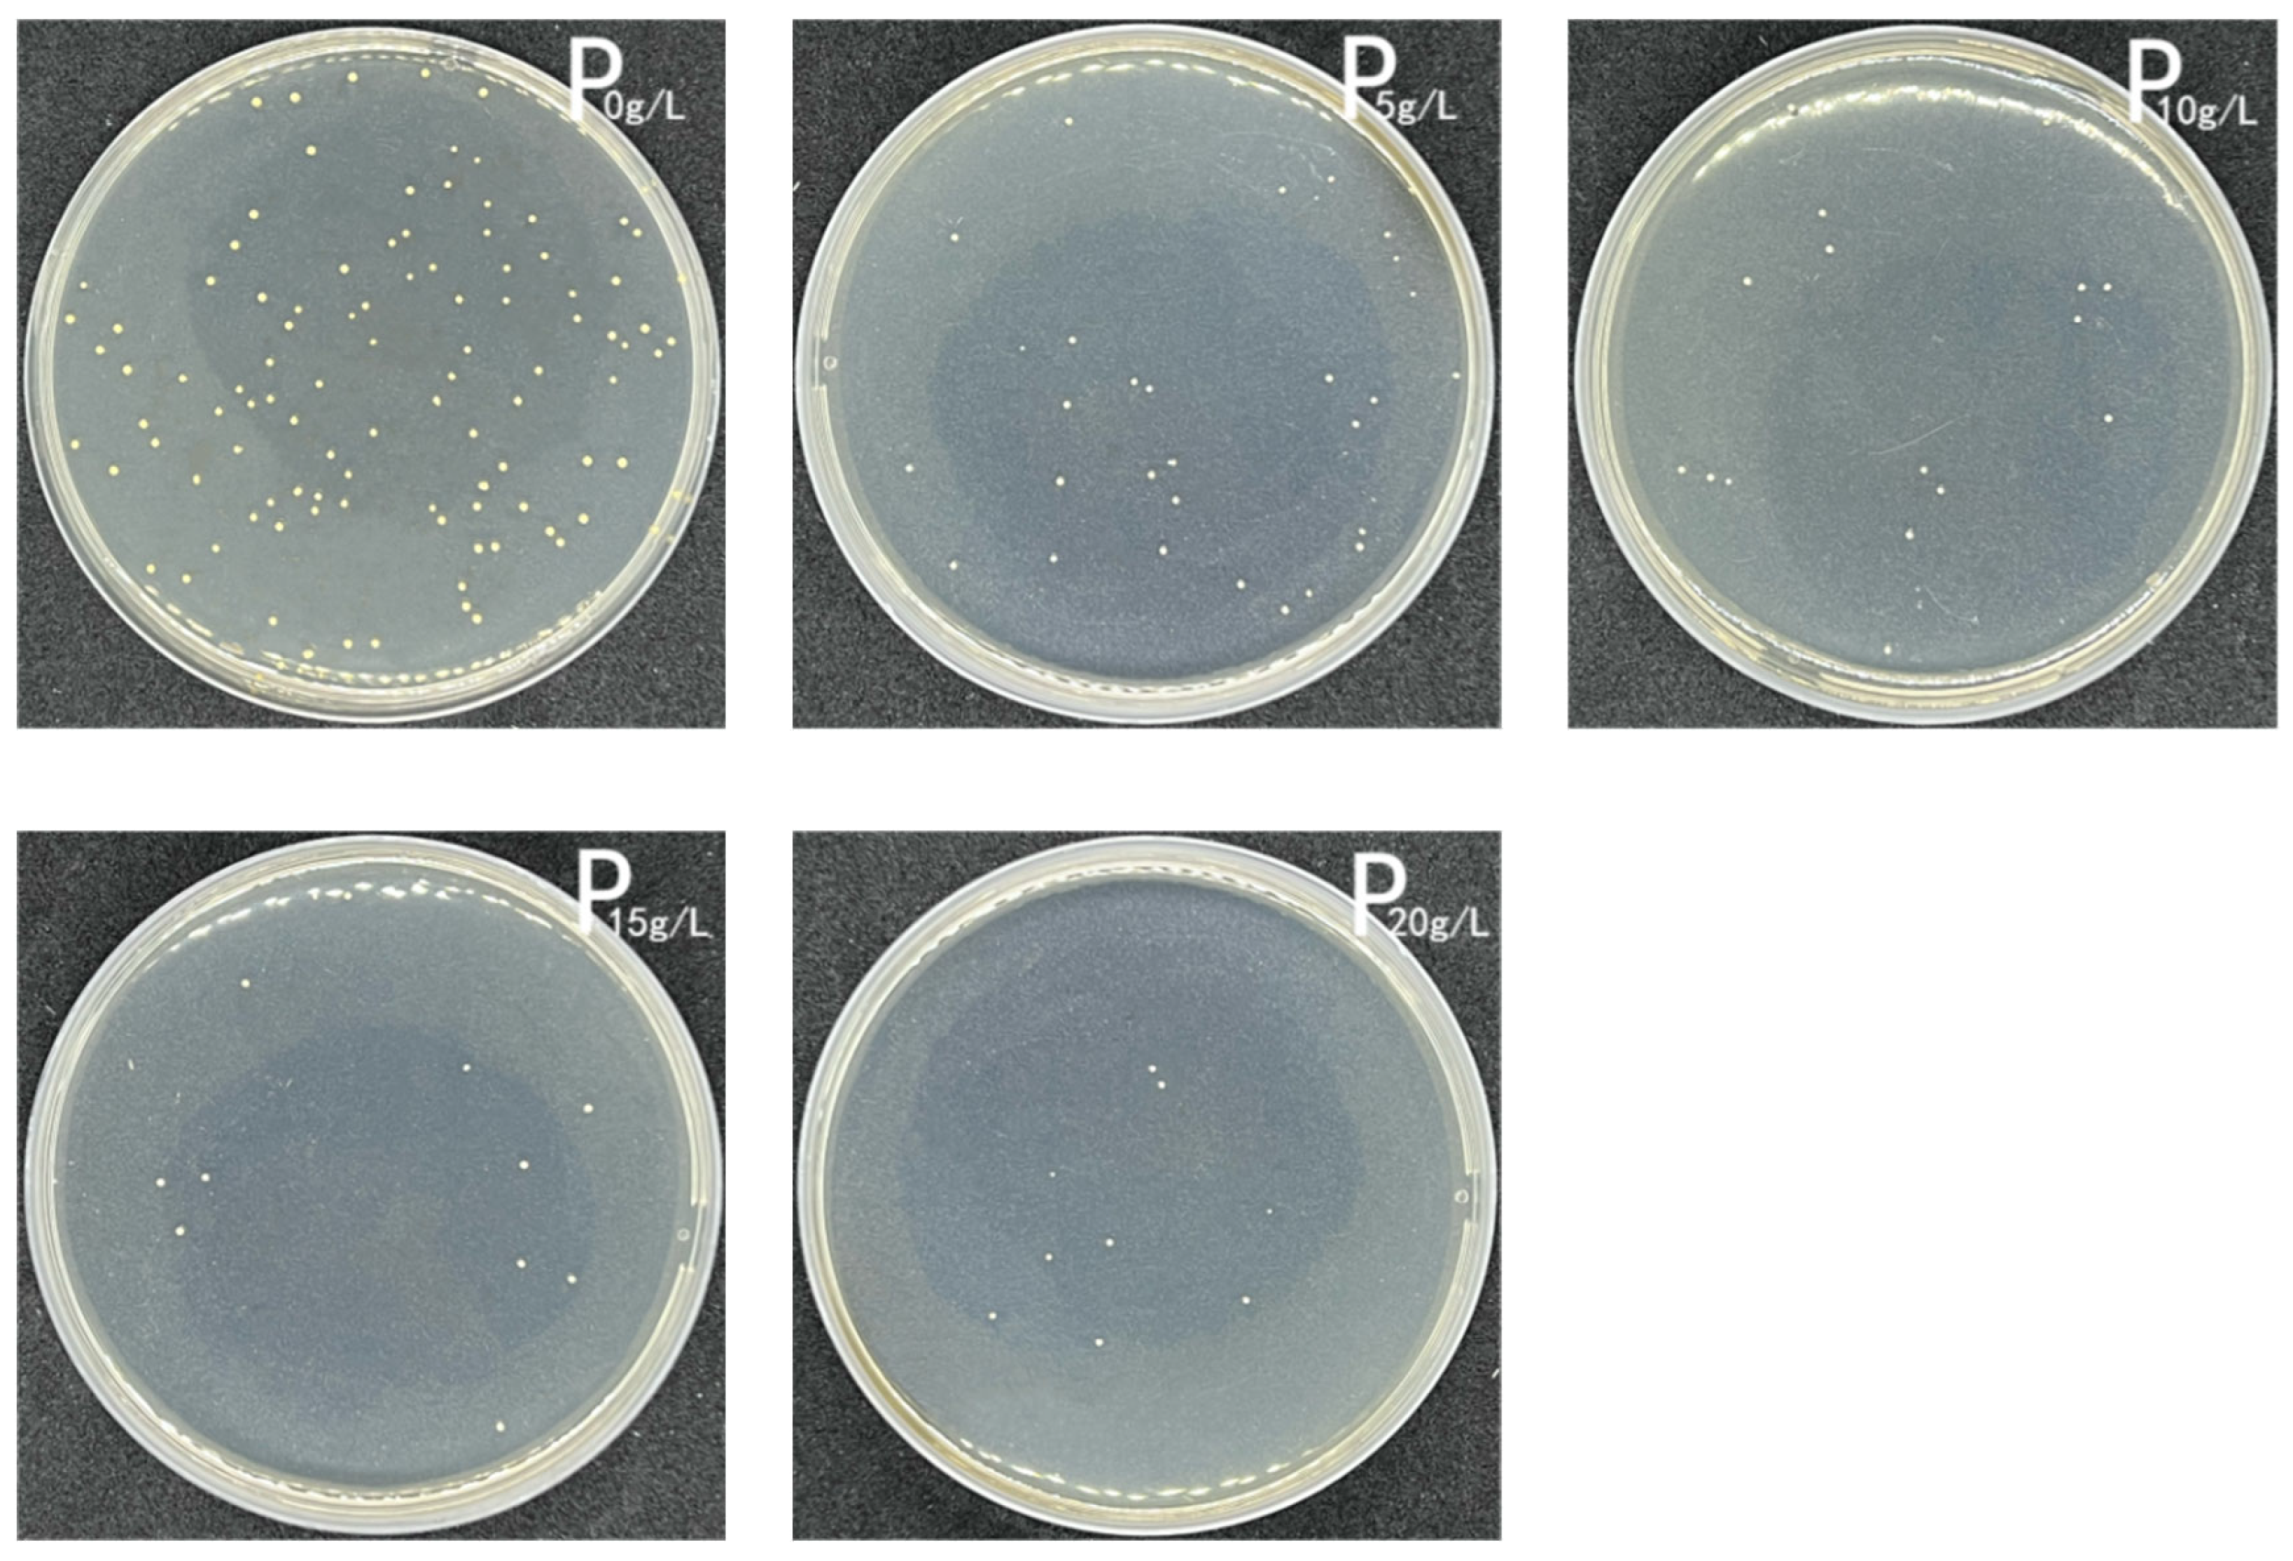
Coatings 13 00714 g013
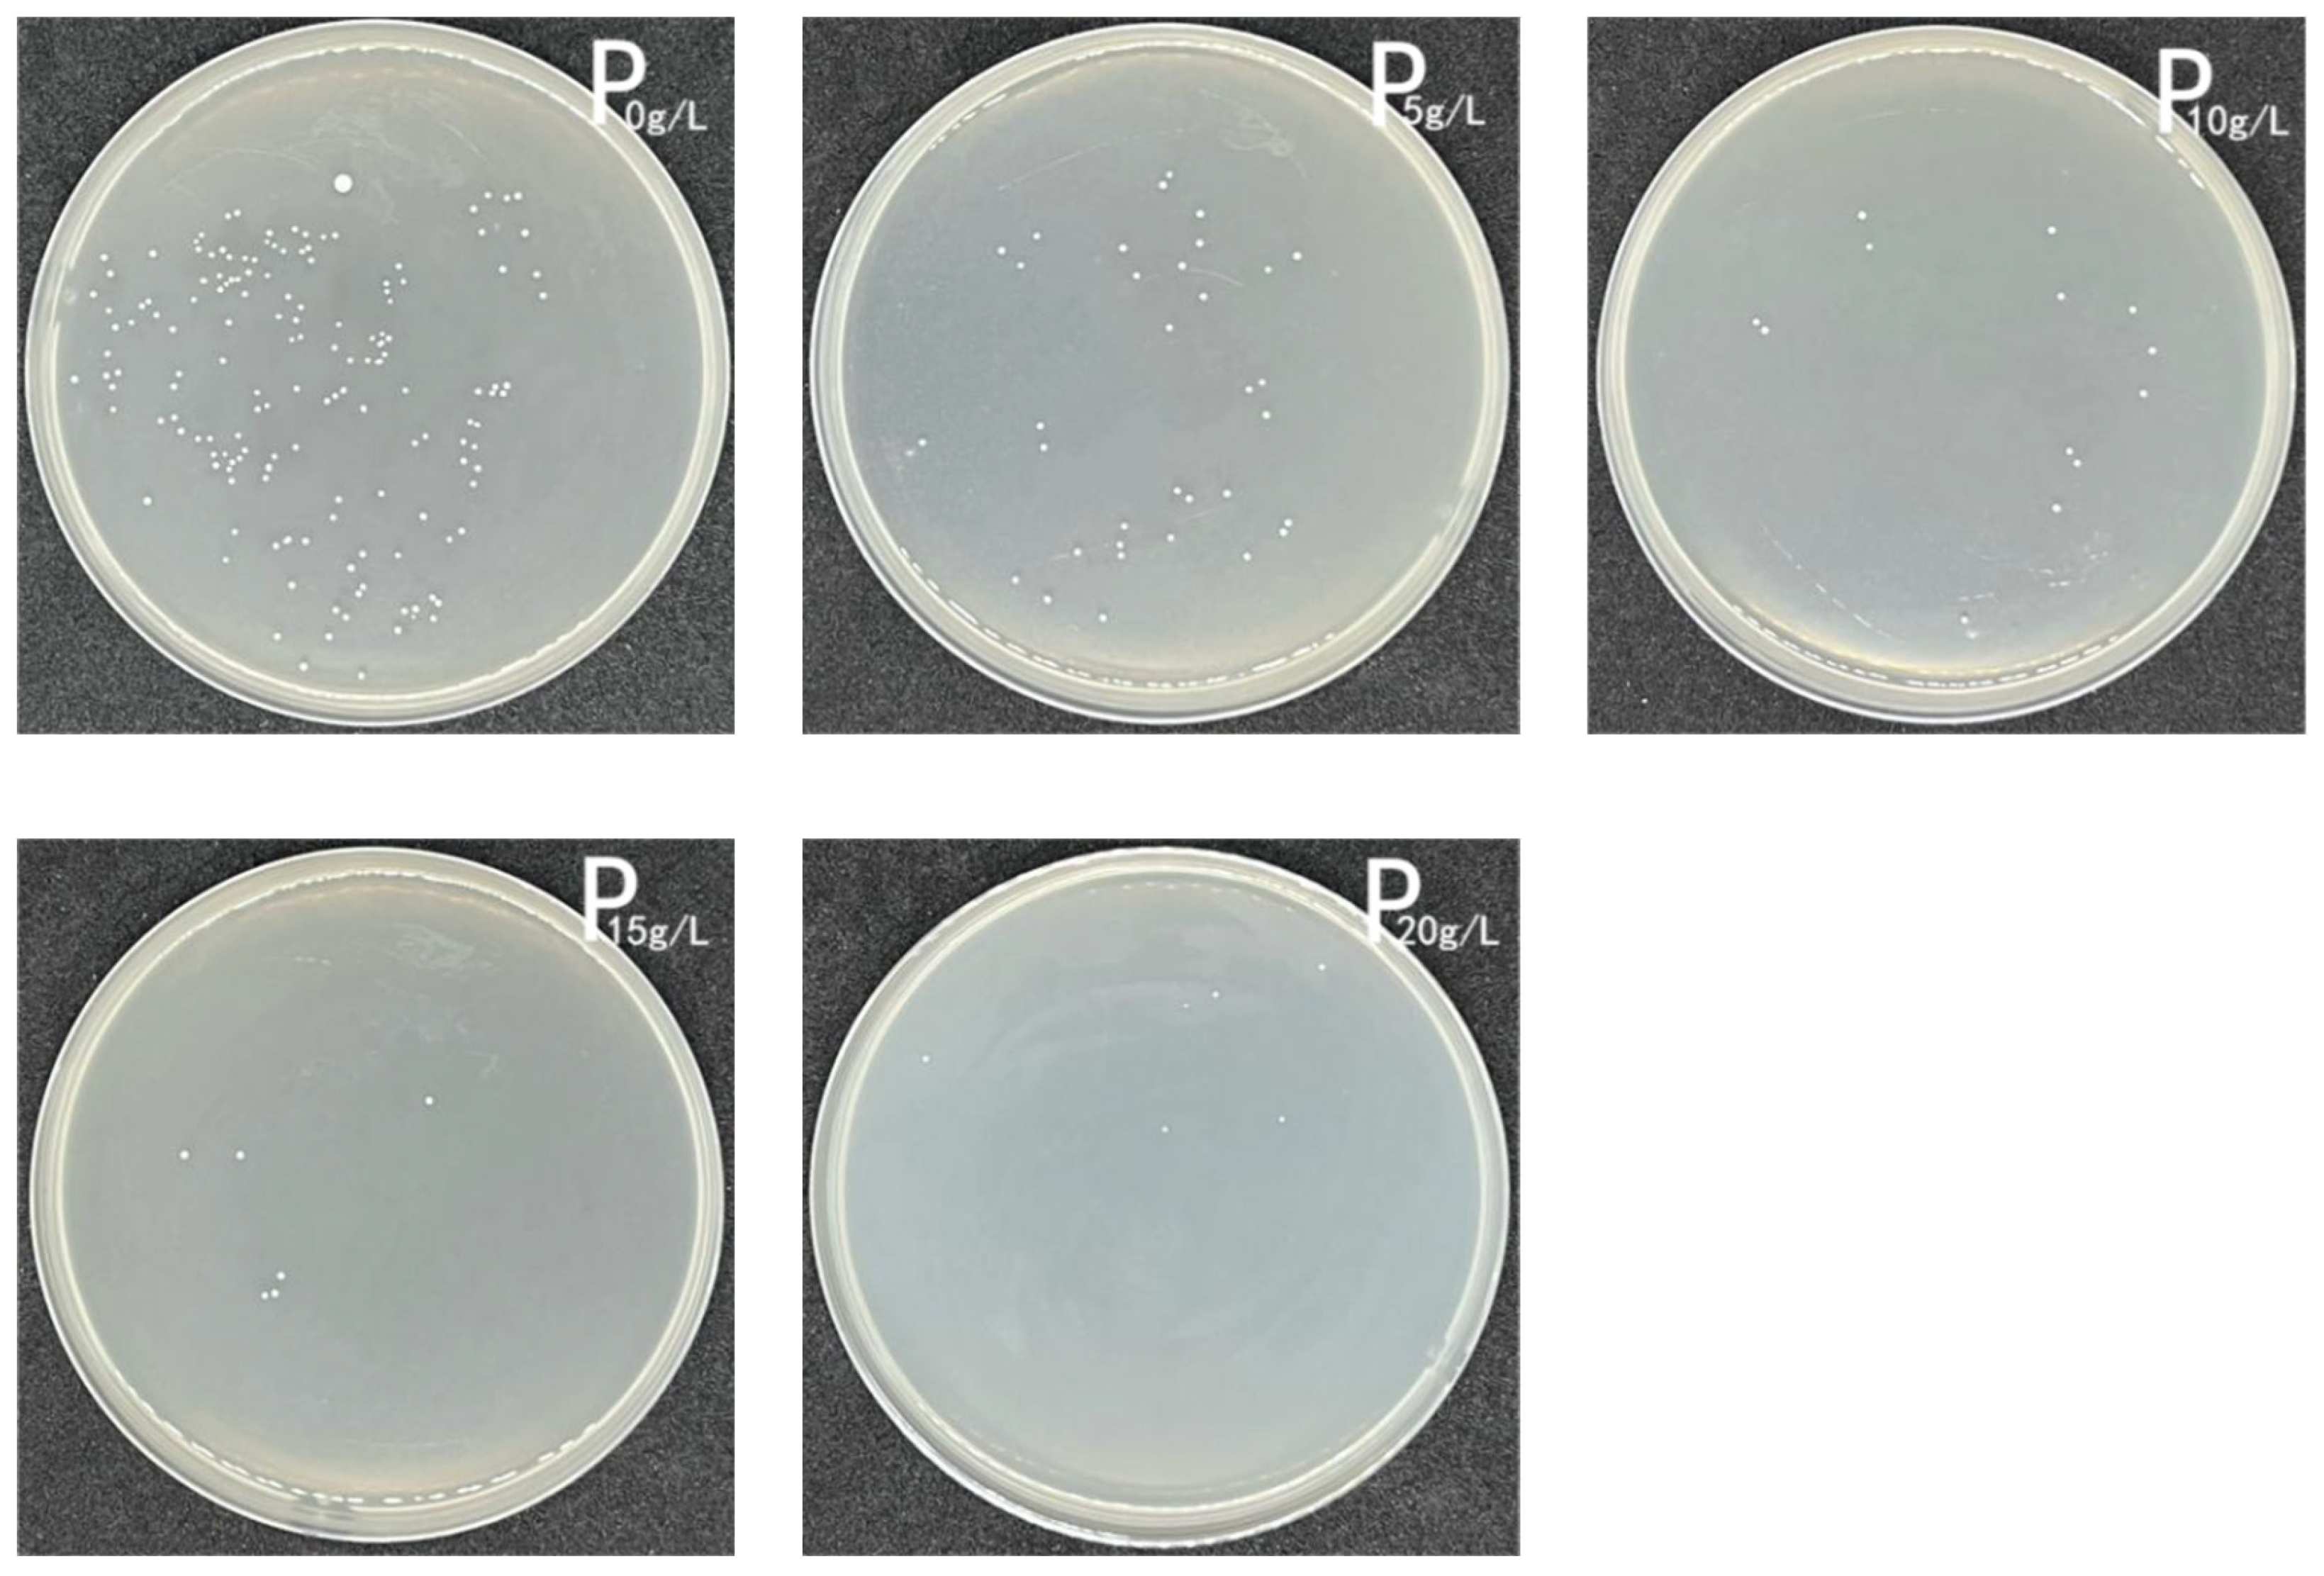
Coatings 13 00714 g014

Development of Antimicrobial Microcapsules of Saffron Petal Essential Oil by Condensation Method and Its Excellent Binding on Cotton Fibers
Abstract
1. Introduction
2. Materials and Methods
2.1. Materials
2.1.1. Reagents
2.1.2. Microorganisms and Growth Conditions
2.2. Pretreatment of Saffron Petals
2.3. Preparation of Saffron Petal Essential Oil (SPEO)
2.3.1. Steam Distillation
2.3.2. Organic Solvent Extraction
2.4. GC–MS Chromatographic Conditions
2.5. Preparation of Saffron Petal Essential Oil Microcapsules (SPEO-Ms)
2.6. Determination of SPEO-M Encapsulation Efficiency
2.7. Surface Morphology of Microcapsules
2.8. Sustained Release Properties of Microcapsules
2.9. Thermogravimetric Analysis
2.10. Fourier Transform Infrared Spectroscopy
2.11. Antimicrobial Properties
2.12. Preparation of Antimicrobial Cotton
2.13. Physical Properties of Antimicrobial Cotton
3. Results and Discussion
3.1. Characterization of SPEO
3.1.1. Effect of Different Extraction Methods on the Essential Oil of Saffron Petals
3.1.2. Analysis of Components
3.1.3. Antimicrobial Capacity of SPEO
3.2. Characterization of SPEO-Ms
3.2.1. UV Standard Curve for SPEO
3.2.2. Microcapsule Structure Analysis
3.2.3. Morphology
3.2.4. Sustained-Release Effect
3.2.5. Thermal Stability
3.2.6. FTIR Analysis
3.2.7. Antimicrobial Activity
3.3. Characterization of Antimicrobial Cotton Knitwear
3.3.1. Surface Morphology
3.3.2. Physical Properties
3.3.3. Antimicrobial Activity
4. Conclusions
Author Contributions
Funding
Institutional Review Board Statement
Informed Consent Statement
Data Availability Statement
Conflicts of Interest
References
- Pavlić, B.; Teslić, N.; Zengin, G.; Đurović, S.; Rakić, D.; Cvetanović, A.; Gunes, A.K.; Zeković, Z. Antioxidant and Enzyme-Inhibitory Activity of Peppermint Extracts and Essential Oils Obtained by Conventional and Emerging Extraction Techniques. Food Chem. 2021, 338, 127724. [Google Scholar] [CrossRef] [PubMed]
 - Aumeeruddy-Elalfi, Z.; Lall, N.; Fibrich, B.; Blom van Staden, A.; Hosenally, M.; Mahomoodally, M.F. Selected essential oils inhibit key physiological enzymes and possess intracellular and extracellular antimelanogenic properties in vitro. J. Food Drug Anal. 2018, 26, 232–243. [Google Scholar] [CrossRef]
 - Fierascu, R.C.; Fierascu, I.C.; Dinu-Pirvu, C.E.; Fierascu, I.; Paunescu, A. The Application of Essential Oils as a Next-Generation of Pesticides: Recent Developments and Future Perspectives. Z. Für Nat. C 2020, 75, 183–204. [Google Scholar] [CrossRef] [PubMed]
 - Esmaeili, Y.; Paidari, S.; Baghbaderani, S.A.; Nateghi, L.; Al-Hassan, A.A.; Ariffin, F. Essential Oils as Natural Antimicrobial Agents in Postharvest Treatments of Fruits and Vegetables: A Review. Food Meas. 2022, 16, 507–522. [Google Scholar] [CrossRef]
 - Semeniuc, C.; Socaciu, M.-I.; Socaci, S.; Mureșan, V.; Fogarasi, M.; Rotar, A. Chemometric Comparison and Classification of Some Essential Oils Extracted from Plants Belonging to Apiaceae and Lamiaceae Families Based on Their Chemical Composition and Biological Activities. Molecules 2018, 23, 2261. [Google Scholar] [CrossRef]
 - Ozdemir, N.; Bayrak, A.; Tat, T.; Yanık, Z.N.; Altay, F.; Halkman, A.K. Fabrication and Characterization of Basil Essential Oil Microcapsule-Enriched Mayonnaise and Its Antimicrobial Properties against Escherichia Coli and Salmonella Typhimurium. Food Chem. 2021, 359, 129940. [Google Scholar] [CrossRef]
 - Kord Heydari, M.; Assadpour, E.; Jafari, S.M.; Javadian, H. Encapsulation of Rose Essential Oil Using Whey Protein Concentrate-Pectin Nanocomplexes: Optimization of the Effective Parameters. Food Chem. 2021, 356, 129731. [Google Scholar] [CrossRef] [PubMed]
 - Chen, X.; Chen, W.; Lu, X.; Mao, Y.; Luo, X.; Liu, G.; Zhu, L.; Zhang, Y. Effect of Chitosan Coating Incorporated with Oregano or Cinnamon Essential Oil on the Bacterial Diversity and Shelf Life of Roast Duck in Modified Atmosphere Packaging. Food Res. Int. 2021, 147, 110491. [Google Scholar] [CrossRef] [PubMed]
 - Al-Moghazy, M.; El-sayed, H.S.; Salama, H.H.; Nada, A.A. Edible Packaging Coating of Encapsulated Thyme Essential Oil in Liposomal Chitosan Emulsions to Improve the Shelf Life of Karish Cheese. Food Biosci. 2021, 43, 101230. [Google Scholar] [CrossRef]
 - Basak, S.; Singh, J.K.; Morri, S.; Shetty, P.H. Assessment and Modelling the Antibacterial Efficacy of Vapours of Cassia and Clove Essential Oils against Pathogens Causing Foodborne Illness. LWT 2021, 150, 112076. [Google Scholar] [CrossRef]
 - Chen, Z.; Gu, J.; Lin, S.; Xu, Z.; Xu, H.; Zhao, J.; Feng, P.; Tao, Y.; Chen, S.; Wang, P. Saffron Essential Oil Ameliorates CUMS-Induced Depression-like Behavior in Mice via the MAPK-CREB1-BDNF Signaling Pathway. J. Ethnopharmacol. 2023, 300, 115719. [Google Scholar] [CrossRef] [PubMed]
 - Aboutorab, M.; Ahari, H.; Allahyaribeik, S.; Yousefi, S.; Motalebi, A. Nano-Emulsion of Saffron Essential Oil by Spontaneous Emulsification and Ultrasonic Homogenization Extend the Shelf Life of Shrimp (Crocus Sativus L.). J. Food Process. Preserv. 2021, 45, e15224. [Google Scholar] [CrossRef]
 - Rajabi, H.; Jafari, S.M.; Rajabzadeh, G.; Sarfarazi, M.; Sedaghati, S. Chitosan-Gum Arabic Complex Nanocarriers for Encapsulation of Saffron Bioactive Components. Colloids Surf. A Physicochem. Eng. Asp. 2019, 578, 123644. [Google Scholar] [CrossRef]
 - Kanakis, C.D.; Daferera, D.J.; Tarantilis, P.A.; Polissiou, M.G. Qualitative Determination of Volatile Compounds and Quantitative Evaluation of Safranal and 4-Hydroxy-2,6,6-Trimethyl-1-Cyclohexene-1-Carboxaldehyde (HTCC) in Greek Saffron. J. Agric. Food Chem. 2004, 52, 4515–4521. [Google Scholar] [CrossRef] [PubMed]
 - Serrano-Díaz, J.; Sánchez, A.M.; Martínez-Tomé, M.; Winterhalter, P.; Alonso, G.L. Flavonoid Determination in the Quality Control of Floral Bioresidues from Crocus Sativus L. J. Agric. Food Chem. 2014, 62, 3125–3133. [Google Scholar] [CrossRef]
 - Termentzi, A.; Kokkalou, E. LC-DAD-MS (ESI+) Analysis and Antioxidant Capacity of Crocus Sativus Petal Extracts. Planta Med. 2008, 74, 573–581. [Google Scholar] [CrossRef]
 - Hosseinzadeh, H.; Younesi, H.M. Antinociceptive and Anti-Inflammatory Effects of Crocus Sativus L. Stigma and Petal Extracts in Mice. BMC Pharmacol. 2002, 2, 7. [Google Scholar] [CrossRef]
 - Akhondzadeh Basti, A.; Moshiri, E.; Noorbala, A.-A.; Jamshidi, A.-H.; Abbasi, S.H.; Akhondzadeh, S. Comparison of Petal of Crocus Sativus L. and Fluoxetine in the Treatment of Depressed Outpatients: A Pilot Double-Blind Randomized Trial. Prog. Neuro-Psychopharmacol. Biol. Psychiatry 2007, 31, 439–442. [Google Scholar] [CrossRef]
 - Fatehi, M.; Rashidabady, T.; Fatehi-Hassanabad, Z. Effects of Crocus Sativus Petals’ Extract on Rat Blood Pressure and on Responses Induced by Electrical Field Stimulation in the Rat Isolated Vas Deferens and Guinea-Pig Ileum. J. Ethnopharmacol. 2003, 84, 199–203. [Google Scholar] [CrossRef]
 - Azarmehr, N.; Afshar, P.; Moradi, M.; Sadeghi, H.; Sadeghi, H.; Alipoor, B.; Khalvati, B.; Barmoudeh, Z.; Abbaszadeh-Goudarzi, K.; Doustimotlagh, A.H. Hepatoprotective Effect of Crocus Sativus (Saffron) Petals Extract against Acetaminophen Toxicity in Male Wistar Rats. Heliyon 2019, 5, e02072. [Google Scholar] [CrossRef]
 - Zheng, C.-J.; Li, L.; Ma, W.-H.; Han, T.; Qin, L.-P. Chemical Constituents and Bioactivities of the Liposoluble Fraction from Different Medicinal Parts of Crocus Sativus. Pharm. Biol. 2011, 49, 756–763. [Google Scholar] [CrossRef] [PubMed]
 - Sutaphanit, P.; Chitprasert, P. Optimisation of Microencapsulation of Holy Basil Essential Oil in Gelatin by Response Surface Methodology. Food Chem. 2014, 150, 313–320. [Google Scholar] [CrossRef] [PubMed]
 - Jyothi, N.V.N.; Prasanna, P.M.; Sakarkar, S.N.; Prabha, K.S.; Ramaiah, P.S.; Srawan, G.Y. Microencapsulation Techniques, Factors Influencing Encapsulation Efficiency. J. Microencapsul. 2010, 27, 187–197. [Google Scholar] [CrossRef] [PubMed]
 - Ju, J.; Xie, Y.; Guo, Y.; Cheng, Y.; Qian, H.; Yao, W. Application of Starch Microcapsules Containing Essential Oil in Food Preservation. Crit. Rev. Food Sci. Nutr. 2020, 60, 2825–2836. [Google Scholar] [CrossRef]
 - Ban, Z.; Zhang, J.; Li, L.; Luo, Z.; Wang, Y.; Yuan, Q.; Zhou, B.; Liu, H. Ginger Essential Oil-Based Microencapsulation as an Efficient Delivery System for the Improvement of Jujube (Ziziphus Jujuba Mill.) Fruit Quality. Food Chem. 2020, 306, 125628. [Google Scholar] [CrossRef]
 - Parthasarathi, S.; Anandharamakrishnan, C. Enhancement of Oral Bioavailability of Vitamin E by Spray-Freeze Drying of Whey Protein Microcapsules. Food Bioprod. Process. 2016, 100, 469–476. [Google Scholar] [CrossRef]
 - Wang, J.; Oussama Khelissa, S.; Chihib, N.-E.; Dumas, E.; Gharsallaoui, A. Effect of Drying and Interfacial Membrane Composition on the Antimicrobial Activity of Emulsified Citral. Food Chem. 2019, 298, 125079. [Google Scholar] [CrossRef]
 - Du, Y.; Mo, L.; Wang, X.; Wang, H.; Ge, X.; Qiu, T. Preparation of Mint Oil Microcapsules by Microfluidics with High Efficiency and Controllability in Release Properties. Microfluid. Nanofluidics 2020, 24, 1–11. [Google Scholar] [CrossRef]
 - Gouin, S. Microencapsulation: Industrial Appraisal of Existing Technologies and Trends. Trends Food Sci. Technol. 2004, 15, 330–347. [Google Scholar] [CrossRef]
 - Wang, X.; Cheng, F.; Wang, X.; Feng, T.; Xia, S.; Zhang, X. Chitosan Decoration Improves the Rapid and Long-Term Antibacterial Activities of Cinnamaldehyde-Loaded Liposomes. Int. J. Biol. Macromol. 2021, 168, 59–66. [Google Scholar] [CrossRef]
 - Chen, S.; Zhang, Z.; Wei, X.; Sui, Z.; Geng, J.; Xiao, J.; Huang, D. Antibacterial and Antioxidant Water-Degradable Food Packaging Chitosan Film Prepared from American Cockroach. Food Biosci. 2022, 49, 101893. [Google Scholar] [CrossRef]
 - Sargın, İ.; Kaya, M.; Arslan, G.; Baran, T.; Ceter, T. Preparation and Characterisation of Biodegradable Pollen–Chitosan Microcapsules and Its Application in Heavy Metal Removal. Bioresour. Technol. 2015, 177, 1–7. [Google Scholar] [CrossRef] [PubMed]
 - Hong, K.H. Preparation and Properties of Multi-Functional Cotton Fabric Treated by Gallnut Extract. Text. Res. J. 2014, 84, 1138–1146. [Google Scholar] [CrossRef]
 - Zheng, H.; Li, X.; Liu, L.; Bai, C.; Liu, B.; Liao, H.; Yan, M.; Liu, F.; Han, P.; Zhang, H.; et al. Preparation of Nanofiber Core-Spun Yarn Based on Cellulose Nanowhiskers/Quaternary Ammonium Salts Nanocomposites for Efficient and Durable Antibacterial Textiles. Compos. Commun. 2022, 36, 101388. [Google Scholar] [CrossRef]
 - Prabhakar, P.; Sen, R.K.; Patel, M.; Dwivedi, N.; Singh, S.; Kumar, P.; Chouhan, M.; Yadav, A.K.; Mondal, D.P.; Solanki, P.R.; et al. Development of Copper Impregnated Bio-Inspired Hydrophobic Antibacterial Nanocoatings for Textiles. Colloids Surf. B Biointerfaces 2022, 220, 112913. [Google Scholar] [CrossRef]
 - Zhou, J.; Wang, Y.; Pan, W.; Xiang, H.; Li, P.; Zhou, Z.; Zhu, M. High Thermal Stability Cu2O@OZrP Micro-Nano Hybrids for Melt-Spun Excellent Antibacterial Activity Polyester Fibers. J. Mater. Sci. Technol. 2021, 81, 58–66. [Google Scholar] [CrossRef]
 - Vishwakarma, A.; Singh, M.; Weclawski, B.; Reddy, V.J.; Kandola, B.K.; Manik, G.; Dasari, A.; Chattopadhyay, S. Construction of Hydrophobic Fire Retardant Coating on Cotton Fabric Using a Layer-by-Layer Spray Coating Method. Int. J. Biol. Macromol. 2022, 223, 1653–1666. [Google Scholar] [CrossRef]
 - Song, X.; Shi, L.; Liu, S.; Hou, C.; Zhu, K.; Cheng, Q.; Mei, L. Development of Microcapsule Bioactive Paper Loaded with Chinese Fir Essential Oil to Improve the Quality of Strawberries. Coatings 2022, 12, 254. [Google Scholar] [CrossRef]
 - İPli̇Kçi̇Oğlu Çi̇L, G.; Küplülü, Ö.; Cengi̇Z, G.; Korkmaz, S.D.; Arslan, B.; Gürcan, S. Antibacterial Activity of Turkish Honey against Selected Foodborne Pathogens. Ank. Üniv. Vet. Fakültesi Derg. 2020, 67, 413–418. [Google Scholar] [CrossRef]
 - Ngamakeue, N.; Chitprasert, P. Encapsulation of Holy Basil Essential Oil in Gelatin: Effects of Palmitic Acid in Carboxymethyl Cellulose Emulsion Coating on Antioxidant and Antimicrobial Activities. Food Bioprocess Technol. 2016, 9, 1735–1745. [Google Scholar] [CrossRef]
 - Kanzler, C.; Haase, P.T.; Schestkowa, H.; Kroh, L.W. Antioxidant Properties of Heterocyclic Intermediates of the Maillard Reaction and Structurally Related Compounds. J. Agric. Food Chem. 2016, 64, 7829–7837. [Google Scholar] [CrossRef] [PubMed]
 - Zhou, Y.; Cao, F.; Luo, F.; Lin, Q. Octacosanol and Health Benefits: Biological Functions and Mechanisms of Action. Food Biosci. 2022, 47, 101632. [Google Scholar] [CrossRef]
 - do Couto, M.V.S.; da Costa Sousa, N.; Paixão, P.E.G.; dos Santos Medeiros, E.; Abe, H.A.; Meneses, J.O.; Cunha, F.S.; Filho, R.M.N.; de Sousa, R.C.; Maria, A.N.; et al. Is There Antimicrobial Property of Coconut Oil and Lauric Acid against Fish Pathogen? Aquaculture 2021, 545, 737234. [Google Scholar] [CrossRef]
 - Ponnusamy, K.; Paul, D.; Kim, Y.S.; Kweon, J.H. 2(5H)-Furanone: A Prospective Strategy for Biofouling-Control in Membrane Biofilm Bacteria by Quorum Sensing Inhibition. Braz. J. Microbiol. 2010, 41, 227–234. [Google Scholar] [CrossRef]
 - Lee, A.R.; Han, C.H.; Yi, E. Preparation and Characterization of Melamine-Formaldehyde Microcapsules Containing Citrus Unshiu Essential Oil. Fibers Polym. 2014, 15, 35–40. [Google Scholar] [CrossRef]
 - Rezaeinia, H.; Ghorani, B.; Emadzadeh, B.; Tucker, N. Electrohydrodynamic Atomization of Balangu (Lallemantia Royleana) Seed Gum for the Fast-Release of Mentha Longifolia L. Essential Oil: Characterization of Nano-Capsules and Modeling the Kinetics of Release. Food Hydrocoll. 2019, 93, 374–385. [Google Scholar] [CrossRef]
 - Bajac, J.; Nikolovski, B.; Lončarević, I.; Petrović, J.; Bajac, B.; Đurović, S.; Petrović, L. Microencapsulation of Juniper Berry Essential Oil (Juniperus Communis L.) by Spray Drying: Microcapsule Characterization and Release Kinetics of the Oil. Food Hydrocoll. 2022, 125, 107430. [Google Scholar] [CrossRef]
 - Muskovics, G.; Felföldi, J.; Kovács, E.; Perlaki, R.; Kállay, T. Changes in Physical Properties during Fruit Ripening of Hungarian Sweet Cherry (Prunus Avium L.) Cultivars. Postharvest Biol. Technol. 2006, 40, 56–63. [Google Scholar] [CrossRef]
 - Duhoranimana, E.; Karangwa, E.; Lai, L.; Xu, X.; Yu, J.; Xia, S.; Zhang, X.; Muhoza, B.; Habinshuti, I. Effect of Sodium Carboxymethyl Cellulose on Complex Coacervates Formation with Gelatin: Coacervates Characterization, Stabilization and Formation Mechanism. Food Hydrocoll. 2017, 69, 111–120. [Google Scholar] [CrossRef]
 - Staroszczyk, H.; Sztuka, K.; Wolska, J.; Wojtasz-Pająk, A.; Kołodziejska, I. Interactions of Fish Gelatin and Chitosan in Uncrosslinked and Crosslinked with EDC Films: FT-IR Study. Spectrochim. Acta Part A Mol. Biomol. Spectrosc. 2014, 117, 707–712. [Google Scholar] [CrossRef]
 - Ghezal, I.; Moussa, A.; Ben Marzoug, I.; El-Achari, A.; Campagne, C.; Sakli, F. Investigating Waterproofness and Breathability of a Coated Double-Sided Knitted Fabric. Coatings 2022, 12, 1572. [Google Scholar] [CrossRef]

| Method of Extraction | Time (h)  | Morphology of Extracts | Extraction Rate (%)  | 
|---|---|---|---|
| Steam distillation | 8 | Pale yellow paste | 0.17 | 
| Organic solvent extraction (n-hexane) | 48 | Tan paste | 2.05 | 
| Organic solvent extraction (petroleum ether) | 48 | Tan paste | 2.57 | 
| Organic solvent extraction (ethanol) | 48 | Dark brown paste | 20.80 | 
| Peak | Compound | Area (%) | |||
|---|---|---|---|---|---|
| Steam Distillation | Organic Solvent Extraction | ||||
| n-Hexane | Petroleum Ether | Ethanol | |||
| 1 | 2(5H)-Furanone | - | - | - | 5.18 | 
| 2 | Methyl 6-oxoheptanoate | - | - | - | 1.72 | 
| 3 | 4H-Pyran-4-one,2,3-dihydro-3,5-dihydroxy-6-methyl- | - | - | - | 24.81 | 
| 4 | 2(3H)-Furanone, dihydro-4-hydroxy- | - | - | - | 1.86 | 
| 5 | 5-Hydroxymethylfurfural | - | - | - | 5.47 | 
| 6 | 2-Dimethylsilyloxytetradecane | - | - | - | 2.38 | 
| 7 | Trioxsalen | - | - | - | 4.64 | 
| 8 | Sucrose | - | - | - | 1.18 | 
| 9 | Dodecanoic acid | 16.96 | - | - | 8.63 | 
| 10 | n-Hexadecanoic acid | 25.33 | 5.01 | 2.97 | 1.08 | 
| 11 | Heptadecanoic acid | - | - | - | 1.18 | 
| 12 | 12,15-Octadecadienoic acid, methyl ester | - | - | - | 12.31 | 
| 13 | Linolic acid | 12.12 | 0.97 | 3.21 | 2.31 | 
| 14 | 11-n-Decyltetracosane | - | - | - | 4.84 | 
| 15 | Octacosane | - | 13.46 | - | 0.89 | 
| 16 | Phthalic acid, dodecyl octyl ester | - | - | - | 3.91 | 
| 17 | 3-Methylheptacosane | - | 19.6 | - | 1.55 | 
| 18 | Octacosanol | - | 4.5 | 1.91 | 16.06 | 
| 19 | 3-Methylnonacosane | - | 2.76 | - | - | 
| 20 | Nonanoic acid | 1.01 | - | - | - | 
| 21 | [1,1′-Bicyclopropyl]-2-octanoic acid, 2′-hexyl-, methyl ester | 0.81 | - | - | - | 
| 22 | Dodecanoic acid, methyl ester | 0.66 | - | - | - | 
| 23 | Dodecanoic acid, TMS derivative | 0.97 | - | - | - | 
| 24 | Tetradecanoic acid | 3.83 | - | - | - | 
| 25 | Cyclopropanebutanoic acid, 2-[[2-[[2-[(2-pentylcyclopropyl)methyl]cyclopropyl]methyl  | 1.25 | - | - | - | 
| 26 | Pentadecanoic acid | 0.97 | - | - | - | 
| 27 | Hexadecanoic acid, methyl ester | 8.89 | - | - | - | 
| 28 | Hexadecanoic acid, 14-methyl-, methyl ester | 1.74 | - | - | - | 
| 29 | Palmitic acid trimethylsilyl ester | 2.47 | - | - | - | 
| 30 | α-Linolenic acid | 0.70 | - | - | - | 
| 31 | methyl linoleate | 13.97 | - | - | - | 
| 32 | Heptadecanoic acid, 16-methyl-, methyl ester | 0.76 | - | - | - | 
| 33 | Icosanal | 0.64 | 1.24 | - | - | 
| 34 | Nitrazepam | 2.06 | - | - | - | 
| 35 | 4,8,12,16-Tetramethylheptadecan-4-olide | 1.01 | 1.79 | - | - | 
| 36 | Tetratetracontane | 1.16 | - | - | - | 
| 37 | Tetracontane | 1.12 | - | - | - | 
| 38 | 1,2-Benzenedicarboxylic acid, isodecyl octyl ester | 1.57 | - | - | - | 
| 39 | Cyclotetradecane | - | 1.12 | - | - | 
| 40 | 1-Hexadecene | - | 1.8 | - | - | 
| 41 | (-)-Epicedrol | - | 0.39 | - | - | 
| 42 | 2-Methylheptacosane | - | 0.91 | - | - | 
| 43 | 1-Nonadecene | - | 1.71 | - | - | 
| 44 | 16-Hexadecanoyl hydrazide | - | 0.45 | - | - | 
| 45 | 1-Docosene | - | 1.23 | - | - | 
| 46 | Heneicosane | - | 1.04 | - | - | 
| 47 | Ethyl linoleate | - | 0.44 | - | - | 
| 48 | n-Tetracosanol-1 | - | 1.05 | - | - | 
| 49 | Octacosane, 2-methyl | - | 4.63 | - | - | 
| 50 | Docosanal | - | 1.61 | - | - | 
| 51 | Nonacosane | - | 26.51 | - | - | 
| 52 | Pentacosane | - | 1.77 | - | - | 
| 53 | 3-Methylpentacosane | - | 1.20 | - | - | 
| 54 | Tetracosane, 11-decyl- | - | 3.97 | - | - | 
| 55 | 19-Heptatriacontanol | - | 0.84 | - | - | 
| 56 | Undecane | - | - | 8.29 | - | 
| 57 | Hexadecane | - | - | 11.38 | - | 
| 58 | Methyl salicylate | - | - | 4.85 | - | 
| 59 | Tetradecane, 2,6,10-trimethyl- | - | - | 9.12 | - | 
| 60 | Dodecane, 2,6,11-trimethyl- | - | - | 10.46 | - | 
| 61 | Tridecane | - | - | 2.74 | - | 
| 62 | 1-Octadecanesulphonyl chloride | - | - | 3.99 | - | 
| 63 | Octadecane, 6-methyl- | - | - | 2.20 | - | 
| 64 | Tetradecane | - | - | 14.71 | - | 
| 65 | Hexadecane, 2,6,11,15-tetramethyl- | - | - | 8.93 | - | 
| 66 | Pentadecane, 2,6,10-trimethyl- | - | - | 2.40 | - | 
| 67 | Eicosane, 2-methyl- | - | - | 6.44 | - | 
| 68 | Docosane | - | - | 1.88 | - | 
| 69 | Heptacosane | - | - | 2.96 | - | 
| 70 | Octadecane, 1-chloro- | - | - | 1.56 | - | 
| Method of Extraction | E. coli (mm) | S. aureus (mm) | C. albicans (mm) | 
|---|---|---|---|
| Steam distillation | - | 12.1 ± 0.7 | - | 
| Organic solvent extraction/(n-hexane) | - | - | - | 
| Organic solvent extraction (petroleum ether) | - | 11.2 ± 0.6 | - | 
| Organic solvent extraction (ethanol) | 11.2 ± 0.4 | 12.4 ± 0.9 | 16.1 ± 1.1 | 
| Sample | Grammage (g)  | Whiteness (%)  | MAP (mm s−1)  | WVP (g m−2 day−1)  | 
|---|---|---|---|---|
| P0 g/L | 1.50 ± 0.13 | 82.11 ± 1.50 | 1658 ± 12.33 | 4233.02 ± 16.33 | 
| P5 g/L | 1.68 ± 0.11 | 61.30 ± 2.23 | 1568 ± 14.20 | 4165.42 ± 17.52 | 
| P10 g/L | 1.82 ± 0.12 | 55.10 ± 2.89 | 1436 ± 11.28 | 4112.65 ± 16.82 | 
| P15 g/L | 1.98 ± 0.08 | 45.33 ± 3.33 | 1262 ± 15.60 | 3998.30 ± 15.21 | 
| P20 g/L | 2.08 ± 0.15 | 44.18 ± 5.50 | 1366 ± 18.63 | 4031.71 ± 8.62 | 
| Sample | E. coli | S. aureus | C. albicans | |||
|---|---|---|---|---|---|---|
| Colony Counting (CFU mL−1 10−6)  | Inhibition Rate (%)  | Colony Counting (CFU mL−1 10−6)  | Inhibition Rate (%)  | Colony Counting (CFU mL−1 10−6)  | Inhibition Rate (%)  | |
| P0g/L | 117 | - | 102 | - | 155 | - | 
| P5g/L | 35 | 70.09 | 30 | 70.59 | 34 | 76.06 | 
| P10g/L | 18 | 84.62 | 14 | 86.27 | 13 | 91.61 | 
| P15g/L | 12 | 88.89 | 10 | 90.20 | 6 | 96.13 | 
| P20g/L | 12 | 88.89 | 9 | 91.18 | 6 | 96.13 | 
Disclaimer/Publisher’s Note: The statements, opinions and data contained in all publications are solely those of the individual author(s) and contributor(s) and not of MDPI and/or the editor(s). MDPI and/or the editor(s) disclaim responsibility for any injury to people or property resulting from any ideas, methods, instructions or products referred to in the content.  | 
© 2023 by the authors. Licensee MDPI, Basel, Switzerland. This article is an open access article distributed under the terms and conditions of the Creative Commons Attribution (CC BY) license (https://creativecommons.org/licenses/by/4.0/).
Share and Cite
Liu, S.; Shi, L.; Liu, M.; Chen, W.; Cheng, Q.; Song, X. Development of Antimicrobial Microcapsules of Saffron Petal Essential Oil by Condensation Method and Its Excellent Binding on Cotton Fibers. Coatings 2023, 13, 714. https://doi.org/10.3390/coatings13040714
Liu S, Shi L, Liu M, Chen W, Cheng Q, Song X. Development of Antimicrobial Microcapsules of Saffron Petal Essential Oil by Condensation Method and Its Excellent Binding on Cotton Fibers. Coatings. 2023; 13(4):714. https://doi.org/10.3390/coatings13040714
Chicago/Turabian StyleLiu, Su, Liuxin Shi, Mengyun Liu, Wei Chen, Qiang Cheng, and Xiuli Song. 2023. "Development of Antimicrobial Microcapsules of Saffron Petal Essential Oil by Condensation Method and Its Excellent Binding on Cotton Fibers" Coatings 13, no. 4: 714. https://doi.org/10.3390/coatings13040714
APA StyleLiu, S., Shi, L., Liu, M., Chen, W., Cheng, Q., & Song, X. (2023). Development of Antimicrobial Microcapsules of Saffron Petal Essential Oil by Condensation Method and Its Excellent Binding on Cotton Fibers. Coatings, 13(4), 714. https://doi.org/10.3390/coatings13040714
        
